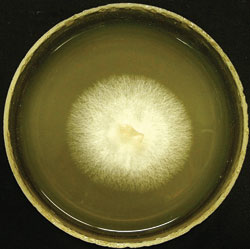
,       .  . .

АНТИБИОТИКИ: ЖИЗНЬ ПРОДОЛЖАЕТСЯ
МЕНЮ
Главная страница
Поиск
Регистрация на сайте
Помощь проекту
Архив новостей
ТЕМЫ
Новости ИИ
Городские сумасшедшие
ИИ в медицине
ИИ проекты
Искусственные нейросети
Искусственный интеллект
Слежка за людьми
Угроза ИИ
ИИ теория
Компьютерные науки
Машинное обуч. (Ошибки)
Машинное обучение
Машинный перевод
Нейронные сети начинающим
Психология ИИ
Реализация ИИ
Реализация нейросетей
Создание беспилотных авто
Трезво про ИИ
Философия ИИ
Генетические алгоритмы
Капсульные нейросети
Основы нейронных сетей
Промпты. Генеративные запросы
Распознавание лиц
Распознавание образов
Распознавание речи
Творчество ИИ
Техническое зрение
Чат-боты
Авторизация
2018-03-07 09:00

Антибиотики вошли в жизнь людей более полувека назад. Благодаря им пневмония, туберкулез, гангрена и другие инфекции перестали быть смертельно опасными для человека. Но даже самые сильные антибиотики не в состоянии уничтожить все болезнетворные бактерии. Природа не терпит пустоты. В борьбе с лекарственными препарата ми бактерии "задействовали" природные генетические механизмы формирования устойчивости. В результате появились новые генерации микробов, на которых не действуют даже самые сильные препараты. С каждым годом "устойчивых" инфекций становится все больше, поэтому усилия медиков всего мира направлены на поиск новых методов борьбы с опасными неуязвимыми бактериями. Ученые московского Научно-исследовательского института по изысканию новых антибиотиков (НИИИНА) им. Г. Ф. Гаузе РАМН добились в этом существенных успехов.
Английский врач Александер Флеминг в 1928 году предположил существование в грибковых микроорганизмах веществ, препятствующих росту бактерий.
В опыте Флеминга грибы вырабатывают вещества, которые подавляют рост бактерий.
Золотистый стафилококк (на фото показан препарат, окрашенный по Грамму) - бактерия, часто становящаяся неуязвимой для антибиотиков.
Г. Ф. Гаузе и М. Г. Бражникова в лаборатории в период работы по созданию первого советского антибиотика грамицидина С. 1940-е годы.

В XIX веке московские власти выделили территорию на Девичьем поле для строительства университетских клиник.

Таблица 1. *Таблицы составлены по данным профессора Яноша Берди (Венгрия), создателя базы данных по антибиотикам и другим биологически активным веществам.
Серно-желтый трутовик образует большое количество органических кислот и не менее трех антибиотиков, эффективных в отношении устойчивых форм стафилококков. Фото Е. Ершовой.

Таблица 2.

Выращенный в лабораторных условиях трутовик дубовой губки по форме напоминает кораллы. Из этого древесного гриба можно получить по меньшей мере четыре антибиотика.
Культура гриба омфалотуса выращивается в лабораторных условиях на жидких средах. В зависимости от условий выращивания и состава питательной среды гриб растет по-разному. Фото О. Ефременковой.
Антибиотик иллудин из пластинчатого гриба омфалотуса признан перспективным для противоопухолевой терапии.

Новый отечественный гликопептидный антибиотик эремомицин выделен из почвенного актиномицета.
В культуре гриба навозника содержатся вещества, способные уничтожать даже устойчивые бактерии золотистого стафилококка. Фото О. Ефременковой.
‹
›
ИСТОРИЯ ОТКРЫТИЯ ВЕЩЕСТВ, УНИЧТОЖАЮЩИХ БАКТЕРИИ
В 1928 году английский врач Александер Флеминг сделал открытие, которое положило начало новой эпохе в медицинской науке. Он обратил внимание на то, что до него наблюдали многие микробиологи, но они не придавали значения обнаруженному явлению. На плотной питательной среде в чашке Петри исследователь выращивал колонии бактерий. Во время эксперимента произошел так называемый "залет": случайно попавшая из воздуха спора гриба положила начало росту грибной колонии среди бактерий. Но самое важное заключалось в том, что вокруг грибковых микроорганизмов бактерии вдруг перестали размножаться. Флеминг предположил, что колония гриба выделяет в питательную среду вещество, препятствующее росту бактерий. Его догадка полностью подтвердилась. Позднее сотрудникам Оксфордского университета британцу Говарду Флори и выходцу из Германии Эрнсту Чейну удалось выделить и определить структуру первого в мире антибактериального вещества, названного пенициллином по имени гриба-продуцента, относящегося к роду пенициллов. Так человечество приобрело орудие борьбы со многими смертельно опасными бактериальными инфекциями. Флеминг, Флори и Чейн в 1945 году получили за свое открытие Нобелевскую премию. За пенициллином последовали открытия других антибактериальных веществ.
Термин "антибиотик" (в переводе с греческого - "против жизни") предложил в 1942 году американский микробиолог, уроженец России, специалист по микробиологии почвы Зельман Ваксман. С его именем связано также открытие другого широко известного антибактериального вещества - стрептомицина, по сей день применяемого для лечения туберкулеза. И пенициллин, и стрептомицин вырабатываются почвенными микроорганизмами (грибы и актиномицеты - две основные группы продуцентов антибиотиков). Но существуют и другие организмы - продуценты антибактериальных веществ. В настоящее время известно около 30 000 антибиотиков природного происхождения, синтезируемых живыми существами различных таксономических групп.
Согласно наиболее распространенному в научном сообществе определению, антибиотиками называются вырабатываемые различными живыми организмами вещества, которые способны уничтожать бактерии, грибы, вирусы, обычные и опухолевые клетки или подавлять их рост. Но это не означает, что все существующие ныне антибиотики произведены живыми клетками. Химики давно научились улучшать, усиливать антибактериальные свойства природных веществ, модифицируя их с помощью химических методов. Полученные таким образом соединения относятся к полусинтетическим антибиотикам. Из огромного количества природных и полусинтетических антибио-тиков в медицинских целях используют всего лишь около ста.
БАКТЕРИИ СОПРОТИВЛЯЮТСЯ
После открытия антибиотиков медики надеялись, что еще немного и человечество навсегда избавится от большинства инфекционных болезней. Но все оказалось не так просто. Дело в том, что примерно через два года после начала широкого применения антибактериального препарата в медицинской практике у болезнетворных бактерий вырабатывается устойчивость к нему. Такая устойчивость, называемая резистентностью, есть ответная наследственно закрепленная реакция микроорганизмов на антибиотики. С биологической точки зрения в соответствии с теорией Дарвина выработка устойчивости не что иное, как результат межвидовой борьбы за существова ние между человеком и патогенной бактерией (или другим организмом-мишенью, на который нацелено применение антибиотика). Как это происходит? Популяции бактерий постоянно видоизменяются; при их размножении возникают различные мутации, в том числе и те, благодаря которым микроорганизмы приобретают резистентность к применяемому препарату. Благодаря высокой скорости размножения и большой численности популяций частота возникновения мутаций, обеспечивающих устойчивость к антибиотику, оказывается достаточно высокой, чтобы выжившие, то есть устойчивые формы компенсировали потери популяции бактерий. Так рождаются новые формы резистентных болезнетворных микроорганизмов. Если человек заразился устойчивым штаммом патогена, то лечить его ранее использовавшимся антибиотиком бесполезно.
Пенициллин начали применять во время Второй мировой войны. Уже тогда медики знали о новых штаммах бактерий, против которых пенициллин оказался бессильным. Ученые выяснили, что устойчивые к этому антибиотику бактерии вырабатывают ферменты пенициллиназы, расщепляющие молекулу пенициллина. Тогда медики занялись разработкой полусинтетических антибиотиков, устойчивых к пенициллиназам. В результате в арсенале врачей появились такие производные пенициллина, как метициллин, оксациллин, диклоксациллин, карбенициллин.
Бактерия с красивым названием "золотистый стафилококк" (Staphylococcus aureus) - один из самых распространенных в человеческой популяции болезнетворных микроорганизмов. Она вызывает различные заболевания: болезни кожи (в том числе пиодермию новорожденных, пузырчатку, дерматиты, абсцессы, фурункулы, панариций и др.), органов дыхания (наиболее распространены ангина, плеврит, пневмония), нервной системы и органов чувств (менингит, отит, конъюнктивит и др.), болезни органов пищеварения (стоматит, перитонит, энтерит, энтероколит, пищевые токсикоинфекции), а также артриты, остеомиелиты, эндокардиты, флебиты, циститы, уретриты, маститы, орхиты и стафилококковый сепсис - первичный или развивающийся на фоне существующих гнойных очагов. Стафилококк - одна из основных, так называемых госпитальных инфекций, возникающая в клиниках разного профиля, но наиболее опасная в роддомах.
Штаммы золотистого стафилококка, устойчивые к пенициллину и его полусинтетическим аналогам, появились уже на стадии клинических испытаний этих препаратов. Среди устойчивых бактериальных популяций - штаммы, на которые не действует метициллин (а также оксациллин). Такие бактерии получили название "метициллинрезистентные" или MRSA (от англ. methicillin resistant Staphylococcus aureus). Механизм возникновения этого типа устойчивости бактерий к антибиотикам связан с мутацией рецепторного белка на поверхности клетки: молекулы антибиотика не могут прикрепиться к клеточной мембране устойчивой бактерии. Штаммы MRSA устойчивы не только к пенициллинам, но и к другой большой группе бета-лактамных антибиотиков - цефалоспоринам. Термин произошел от названия плесневого гриба цефалоспориума (Cephalosporium), из которого впервые выделили соединение этого класса. Позднее цефалоспорины были обнаружены у ряда грибов, а также у актиномицетов и бактерий. А ведь пенициллины и цефалоспорины до недавнего времени применялись в медицинской практике наиболее часто. Более того, некоторые штаммы золотистого стафилококка в последние годы приобрели устойчивость сразу ко многим антибиотикам. Такие сверхустойчивые популяции бактерий обозначают английской аббревиатурой MDR (multidrug resistant). Сейчас в арсенале медиков для борьбы с MDR-штаммами имеется антибиотик ванкомицин. Но все чаще и чаще встречаются патогенные бактерии, неуязвимые к воздействию практически всех известных препаратов. Количество штаммов, которые "не берет" ни одно лекарство, сейчас достигает 2% от всех случаев стафилококковой инфекции.
Устойчивость к лекарственным препаратам приобретают и бактерии других видов. Например, синегнойная палочка (Pseudomonas aeruginosa), распространенный возбудитель госпитальных инфекций, вызывает тяжелые раневые и ожоговые инфекции, разнообразные воспалительные и геморрагические явления, преимущественно у маленьких детей и у взрослых с ослабленным иммунитетом. По данным ведущего российского специалиста по эпидемиологии резистентности профессора С. В. Сидоренко, для лечения примерно 20% штаммов синегнойной палочки в настоящее время эффективных антибиотиков нет, то есть каждого пятого пациента лечить просто нечем.
ПРЕДПОСЫЛКИ ПОЯВЛЕНИЯ НЕУЯЗВИМЫХ БАКТЕРИЙ Штаммы устойчивых болезнетворных бактерий появляются в местах скопления людей с ослабленным иммунитетом. Поэтому чаще всего суперустойчивые бактерии встречаются в больницах, роддомах, домах престарелых, тюрьмах. Отсюда и термин "госпитальные", или "внутрибольничные", инфекции. Чем дольше пациент находится в клинике, тем выше вероятность заражения госпитальными инфекциями.
Распространенность таких больничных инфекций зависит от страны, региона и меняется со временем. Так, в США средняя частота возникновения госпитальных инфекций в отделениях реанимационной педиатрии составляет 6,1%, а во Франции - 23,5%. В клиниках Москвы и Санкт-Петербурга частота встречаемости устойчивой формы стафилококка MRSA в 1998 году составляла от 0 до 40%, а теперь в отдельных столичных больницах доходит до 80%.
Кроме того, патогенные микроорганизмы, устойчивые к большинству антибиотиков, в последнее время стали распространяться среди вполне здоровых людей. Процесс очень трудно контролировать и еще труднее предотвратить. Так, в США ученые обнаружили, что устойчивые штаммы золотистого стафилококка MRSA распространяются среди спортсменов, вступающих в непосредственный контакт (например, среди борцов) или соприкасающихся с каким-то общим предметом, например с мячом, как это происходит при игре в гандбол или баскетбол. Описаны случаи распространения MRSA в школьных спортивных командах.
Чем шире используются антибиотики, тем чаще возникают и распространяются бактерии, потерявшие к ним чувствительность. Поэтому особенно опасно неконтролируемое применение антибактериальных препаратов без предписания врача. Зачастую при самостоятельно поставленном диагнозе "простуда" многие начинают принимать антибиотики, предназначенные для лечения бактериальных инфекций. Но не следует забывать, что за так называемой простудой могут скрываться самые разные инфекционные заболевания, в том числе и вирусные (например, грипп), против которых применять антибактериальные препараты не просто бесполезно, а даже вредно. Эффекта от такого лечения никакого, но в организме нарушается естественная бактериальная флора, в результате чего могут развиться оппортунистические инфекции, например кандидоз (неконтролируемый рост дрожжевых грибов рода Candida). Кроме того, возникает ничем не оправданный риск появления в организме устойчивых бактериальных штаммов.
Другая распространенная ошибка при лечении заключается в том, что больной при улучшении самочувствия раньше времени отказывается от выписанного антибиотика или принимает его в более низкой дозе по сравнению с назначенной врачом. Это опасно тем, что приводит к увеличению вероятности выработки лекарственной устойчивости у болезнетворной бактерии; следовательно, последующая попытка лечения этим же антибиотиком будет неэффективна.
Иногда при лечении антибактериальными препаратами устойчивость к лекарствам вырабатывается у бактерий, составляющих микрофлору человека. Такие "свои" устойчивые бактерии могут передавать гены резистентности чужеродным бактериям, вызывающим различные болезни. В результате межвидового обмена генами возбудители инфекции тоже становятся устойчивыми.
С УСТОЙЧИВОСТЬЮ БАКТЕРИЙ МОЖНО БОРОТЬСЯ С возникновением и распространением устойчивых штаммов микроорганизмов борются, регулируя применение антибиотиков. Во многих развитых странах антибиотики отпускают строго по рецептам. Принимаются и другие меры. В настоящее время во всем мире запрещено использовать антибиотики медицинского назначения для консервации продуктов питания. Забой скота, подвергавшегося лечению антибиотиками или получавшего их в качестве стимуляторов роста, должен производиться по истечении времени выведения лекарств из организма животного, то есть в поступающем в продажу мясе не должно быть и следов препарата.
Другой подход к проблеме резистентности - создание новых лекарственных препаратов, способных побороть бактерии, ставшие устойчивыми к давно использующимся лекарствам. На разработку и внедрение нового антибиотика в среднем уходит 10 лет. Но несмотря на этот внушительный срок, научные коллективы и фармацевтические компании во многих странах мира продолжают заниматься выделением и синтезом новых антибактериальных веществ.
Насколько же осуществима задача поиска новых природных антибиотиков? Выше упоминалось, что основные известные продуценты антибактериальных соединений - это почвенные микроорганизмы - актиномицеты, бактерии и грибы. Начиная с 1950-х и по 1990-е годы исследова тели шли по "проторенной дорожке", продолжая заниматься поиском новых антибиотиков в одних и тех же живых микроорганизмах. Это можно объяснить не только инертностью мышления, но еще и тем, что в те годы промышленная база позволяла нарабатывать в ферментерах на жидких питательных средах огромное количество микробной массы почвенных микроорганизмов, производящих антибиотики.
Но наука не стоит на месте, и в последние пятнадцать-двадцать лет спектр организмов - продуцентов антибиотиков расширился (см. табл. 1). Среди них теперь числятся не только почвенные микробы, но также многие виды растений и животных. Как потенциальные производители антибиотиков очень перспективны высшие грибы, особенно те, которые можно культивировать в искусственных условиях. Развитие генетической инженерии не только делает такие объекты интересными в теоретическом плане, но и позволяет создавать рентабельные биотехнологические способы производства. Для получения больших количеств природных антибиотиков теперь вовсе не обязательно выращивать и перерабатывать тонны биомассы (живых организмов и высших растений). Антибактериальные вещества можно получать, встраивая гены "нужного" антибиотика в геном бактерий. В процессе жизнедеятельности бактерии нарабатывают желаемое лекарственное вещество, превращаясь в своеобразную фармацевтическую фабрику по производству антибиотиков.
В качестве примера растения - продуцента антибиотиков можно привести тихоокеанский тис. Из его коры выделяют таксол - противораковый антибиотик, применяемый для лечения рака яичников. Содержание таксола в коре тиса составляет всего лишь тысячные доли процента, поэтому одна терапевтическая доза препарата поначалу стоила около тысячи долларов. Сегодня цена значительно упала благодаря разработке способа получения таксола биотехнологическими методами.
С развитием молекулярно-биологических методов получения природных соединений поиск новых антибиотиков даже в организмах высших животных и растений стал вполне экономически оправданным. Причем диапазон поиска практически не ограничен. По оценке венгерского профессора Яноша Берди, исследовавшиеся в той или иной степени живые организмы (а это не означает, что все они досконально изучены на молекулярном уровне) составляют лишь малую часть биоразнообразия нашей планеты (см. табл. 2). Ученый считает, что из существующих в природе 8-10 миллионов видов насекомых описана лишь десятая часть, из полутора миллионов бактерий - шесть тысяч.
В наше время удается даже открывать новые виды позвоночных животных, а уж не- открытых микроорганизмов вообще великое множество. Например, из почвы при использовании традиционных микробиологических методов высевается не более 0,1-10% присутствующих там микроорганизмов. Оставшиеся (так называемые "живые, но некультивируемые" микроорганизмы) еще не в полной мере изучены и представляют собой практически неисчерпаемый источник продуцентов новых антибиотиков.
ОТ ГРАМИЦИДИНА К ЭРЕМОМИЦИНУ В нашей стране разработка антибактериальных препаратов началась еще до Великой Отечественной войны. Первый отечественный оригинальный антибиотик грамицидин С (грамицидин советский), выделенный из почвенной бактерии Bacillus brevis var. G.-B., был открыт Георгием Францевичем Гаузе и Марией Георгиевной Бражниковой в 1942 году, а использовать его начали уже во время войны. Этот антибиотик применяется и в настоящее время, он широко известен под торговым названием грамидин.
В 1953 году в Советском Союзе на базе лаборатории антибиотиков АМН СССР был создан Научно-исследовательский институт по изысканию новых антибиотиков Российской академии медицинских наук, теперь носящий имя Г. Ф. Гаузе, который инициировал исследования по поиску новых лекарственных соединений. Всего на протяжении первых тридцати лет деятельности института ученые внедрили в медицинскую практику 16 антибактериальных и противоопухолевых антибиотиков. В тяжелые перестроечные годы институт возглавлял ученик Г. Ф. Гаузе член-корреспондент РАМН Юрий Васильевич Дудник. Благодаря его усилиям удалось практически полностью сохранить научные кадры и не прервать исследования, а этим, к сожалению, может похвастаться далеко не каждое научное учреждение. Сейчас институт возглавляет профессор Мария Николаевна Преображенская, известный в мире специалист по химической трансформации антибиотиков.
Основными объектами поиска новых антибактериальных веществ в институте долгие годы были почвенные бактерии актиномицеты, а в последние годы к ним прибавились высшие грибы. Под руководством профессора Ларисы Петровны Тереховой разработаны способы селективного выделения актиномицетов из почвы, позволяющие выращивать виды, обычно не культивируемые в лабораторных условиях. Например, облучение почвы ультрафиолетом, сверхвысокочастотными (СВЧ) и крайне высокочастотными (КВЧ) электромагнитными волнами дает возможность во много раз повысить вероятность выделения представителей редких родов актиномицетов. Это очень важно, поскольку, например, продуцент нового антибиотика даптомицина встречается с частотой одна бактерия на десять миллионов.
С помощью новых методов в нашем институте за последние четыре года было исследовано 9280 выделенных из природной среды организмов. 1169 из них содержали антибиотики, эффективные по отношению к устойчивому штамму золотистого стафилококка MRSA. Ученые признали наиболее перспективными с фармацевтической точки зрения 265 веществ и исследовали их химический состав. Из них идентифицировано 28 уже известных ранее антибиотиков, а 36 признаны новыми соединениями. Но только лишь семь новых антибиотиков показали высокий терапевтический эффект и низкую токсичность в опытах на животных.
Высшие грибы тоже признаны перспективными продуцентами антибиотиков. Например, в 1950 году был описан антибактериальный антибиотик широкого спектра действия иллудин. Это соединение образуется пластинчатым грибом омфалотусом Omphalotus olearius, растущим на коре, на пнях или на земле около оливковых деревьев, а также возле деревьев некоторых других лиственных пород. Однако из-за высокой токсичности в качестве лекарства этот антибиотик тогда не был востребован. В последние годы в США снова начали проводиться интенсивные исследования лечебного действия иллудина и его синтетических производных. Препарат стал одним из так называемых старых новых антибиотиков, которых в последнее время появилось достаточно много. Оказалось, что производные иллудина обладают избирательным действием в отношении ряда опухолевых клеток. Ученые НИИИНА работают также со штаммом омфалотуса, производящим иллудин, из коллекции культур шляпочных грибов Института ботаники им. Н. Г. Холодного Национальной академии наук Украины.
Другой пример продуцента антибиотиков - хорошо известный гриб вешенка (Pleurotus ostreatus). Подобно омфалотусу, вешенка растет на отмершей древесине и на ослабленных деревьях. Сотрудники НИИИНА обнаружили, что данный вид вырабатывает не менее восьми антибиотиков различной химической природы и антимикробного действия. Каскад биосинтеза лекарственных веществ начинается на четвертые-пятые сутки культивирования гриба в жидкой среде и продолжается на протяжении трех недель. Интересно, что первой в процессе культивации проявляется и затем исчезает антигрибковая активность, которая в природе помогает вешенке конкурировать с другими грибами за источник питания (древесину).
Еще один гриб, серно-желтый трутовик, или "цыпленок на дереве" (Laetiporus sulphureus), также вырабатывает не менее трех антибиотиков. Они эффективны в отношении устойчивых форм стафилококков. Другой древесный высший гриб, в котором российские исследователи впервые обнаружили четыре антибиотика, - дубовая губка (Daedalea quercina).
Антибактериальные вещества были найдены не только в древоразрушающих видах грибов, но и в копрофилах - навозниках (род Coprinus). В большинстве своем это мелкие с тонкой мякотью шляпочные грибы, плодовые тела которых живут от нескольких часов до нескольких суток, а затем расплываются в чернильную жидкую массу. Еще сто лет назад из таких расплывшихся шляпок делали чернила, представлявшие собой суспензию темных спор. Подпись на документах, поставленная такими чернилами, имела дополнительную степень надежности: ее сложно подделать потому, что споры конкретного вида копринуса, видимые под лупой, отличаются по форме и размеру от спор других копринусов, то есть это были чернила "с секретом". Теперь в копринусе Coprinus congregatus найден новый антибиотик, относящийся к группе немотина, а в навознике Coprinus lagopu - лагоподин В, не токсичный и эффективный в отношении штаммов устойчивого золотистого стафилококка MRSA.
Благодаря работе ученых НИИИНА в России после 20-летнего перерыва наконец налаживается промышленный выпуск нового гликопептидного антибиотика эремомицина. Это семнадцатая разработка за полувековое существование института. Внедрению предшествовал долгий путь: сначала из почвы выделили штамм актиномицета, затем идентифицировали его таксономическую принадлежность (Amycolatopsis orientalis subsp. eremomycini), установили спектр чувствительных к нему микроорганизмов, отработали процедуру выделения, установили химическое строение антибиотика, провели селекцию, позволившую во много раз повысить продуктивность исходного штамма ("дичка") и создать на его основе промышленный штамм-продуцент, разработали технологию биосинтеза нового антибиотика, изучили его действие in vivo на животных , провели клинические испытания. Новый отечественный антибиотик эремомицин эффективен в отношении многих устойчивых форм патогенных бактерий, в том числе и золотистого стафилококка MRSA.
Феномен бактериальной устойчивости не дает ученым и производителям долго "почивать на лаврах", а требует разработки и внедрения новых и новых эффективных препаратов. К сожалению, в России последние 20 лет биотехнологическая промышленность и связанное с ней производство медикаментов находились в состоянии упадка. Отечественные производители в лучшем случае решались на выпуск так называемых дженериков - аналогов зарубежных лекарств, срок лицензии которых уже истек. Между тем и с точки зрения развития передовых технологий, и с точки зрения национальной безопасности разработка и внедрение новых антибиотиков в ближайшие десятилетия должны стать одним из приоритетных направлений российской науки и технологии.
Телеграм: t.me/ainewsline
Источник: www.nkj.ru
